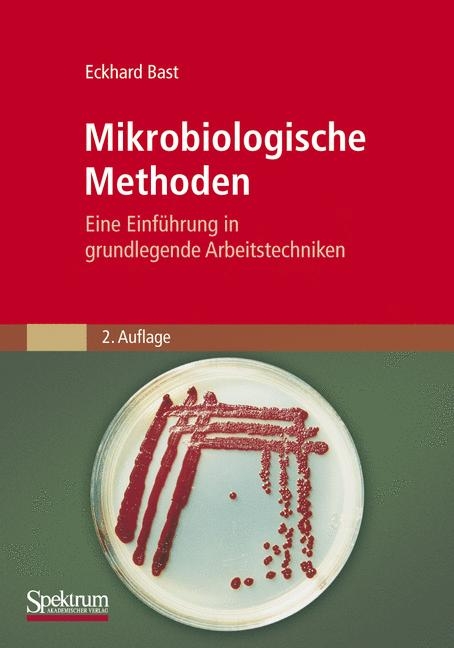
Mikrobiologische Methoden - Eckhard Bast

Mikrobiologische Methoden
Eine Einführung in grundlegende Arbeitstechniken
Seiten
2001
|
2., Aufl. 2001. Korr. Nachdruck 2nd Printing.
Spektrum Akademischer Verlag
978-3-8274-1072-6 (ISBN)
Spektrum Akademischer Verlag
978-3-8274-1072-6 (ISBN)
- Titel erscheint in neuer Auflage
- Artikel merken
Mikroorganismen sind wichtige Objekte der Forschung und Werkzeuge der Gentechnologie. Sie stellen nützliche Helfer in Landwirtschaft und Industrie und bei der Mineralisation von Abfall- und Schadstoffen dar. Sie verursachen jedoch auch Krankheiten, den Verderb von Lebensmitteln und die Zersetzung von Werkstoffen. Die Beschäftigung mit ihnen und ihren unterschiedlichen Aktivitäten setzt die Kenntnis grundlegender mikrobiologischer Methoden voraus. Genau diese vermittelt das vorliegende Buch, leicht verständlich und praxisnah.
Das Buch richtet sich an Studierende und Dozenten der Biologie, Biotechnologie und Medizin, an Biologielehrer, an technische Assistenten und an Wissenschaftler in Forschung, Industrie und Untersuchungslabors. Es bietet
· präzise und reproduzierbare "Man-nehme"-Vorschriften der wichtigsten mikrobiologischen Methoden
· die theoretischen Grundlagen und Hinweise zur Auswertung, zur Leistungsfähigkeit und zu den Grenzen der behandelten Arbeitstechniken
· Erläuterungen zu Bau und Funktion der benötigten Geräte und zu den Eigenschaften der eingesetzten Materialien sowie ein ausführliches Bezugsquellenverzeichnis
· eine Beschreibung der gebräuchlichen Sterilisationsverfahren und des sterilen Arbeitens
· wichtige Informationen zu Nährböden und Kulturgefäßen
· Anleitungen zur Anreicherung, Isolierung und Kultivierung einzelliger Mikroorganismen
· Angaben zur Beschaffung und Aufbewahrung von Reinkulturen
· eine Darstellung lichtmikroskopischer Untersuchungsverfahren und Färbetechniken
· einen Überblick über Methoden der Zellzahl- und Biomassebestimmung bei Bakterien und Hefen.
Dieses Buch wird sich bald als unentbehrlicher Begleiter für alle erweisen, die erste Erfahrungen im Umgang mit Mikroorganismen, insbesondere mit Bakterien, sammeln oder sich über die gängigen Standardmethoden informieren wollen oder Arbeitsunterlagen für die praktische mikrobiologische Ausbildung suchen.
Für die 2. Auflage wurde der Text durchgesehen und das Literaturverzeichnis auf den neuesten Stand gebracht. Druckfehler wurden korrigiert, kleinere Ergänzungen vorgenommen, Adressen, Bakteriennamen sowie gesetzliche Bestimmungen wurden aktualisiert.
Das Buch richtet sich an Studierende und Dozenten der Biologie, Biotechnologie und Medizin, an Biologielehrer, an technische Assistenten und an Wissenschaftler in Forschung, Industrie und Untersuchungslabors. Es bietet
· präzise und reproduzierbare "Man-nehme"-Vorschriften der wichtigsten mikrobiologischen Methoden
· die theoretischen Grundlagen und Hinweise zur Auswertung, zur Leistungsfähigkeit und zu den Grenzen der behandelten Arbeitstechniken
· Erläuterungen zu Bau und Funktion der benötigten Geräte und zu den Eigenschaften der eingesetzten Materialien sowie ein ausführliches Bezugsquellenverzeichnis
· eine Beschreibung der gebräuchlichen Sterilisationsverfahren und des sterilen Arbeitens
· wichtige Informationen zu Nährböden und Kulturgefäßen
· Anleitungen zur Anreicherung, Isolierung und Kultivierung einzelliger Mikroorganismen
· Angaben zur Beschaffung und Aufbewahrung von Reinkulturen
· eine Darstellung lichtmikroskopischer Untersuchungsverfahren und Färbetechniken
· einen Überblick über Methoden der Zellzahl- und Biomassebestimmung bei Bakterien und Hefen.
Dieses Buch wird sich bald als unentbehrlicher Begleiter für alle erweisen, die erste Erfahrungen im Umgang mit Mikroorganismen, insbesondere mit Bakterien, sammeln oder sich über die gängigen Standardmethoden informieren wollen oder Arbeitsunterlagen für die praktische mikrobiologische Ausbildung suchen.
Für die 2. Auflage wurde der Text durchgesehen und das Literaturverzeichnis auf den neuesten Stand gebracht. Druckfehler wurden korrigiert, kleinere Ergänzungen vorgenommen, Adressen, Bakteriennamen sowie gesetzliche Bestimmungen wurden aktualisiert.
Dr. Eckhard Bast ist erfahrener Kursleiter am Institut für Mikrobiologie und Biotechnologie der Rheinischen Friedrich-Wilhelms-Universität in Bonn.
1 Einleitung
2 Erste Hilfe bei Laborinfektionen
3 Sterilisation und Keimreduzierung
4 Steriles Arbeiten - Sicherheit im Labor
5 Kultivierung von Mikroorganismen
6 Anreicherung und Isolierung von Mikroorganismen
7 Aufbewahrung und Beschaffung von Reinkulturen
8 Lichtmikroskopische Untersuchung von Mikroorganismen
9 Bestimmung der Zellzahl und Zellmasse in Populationen einzelliger Mikroorganismen
| Sprache | deutsch |
|---|---|
| Maße | 168 x 240 mm |
| Gewicht | 721 g |
| Einbandart | Paperback |
| Themenwelt | Medizin / Pharmazie ► Gesundheitsfachberufe ► MTA - Labor |
| Naturwissenschaften ► Biologie ► Mikrobiologie / Immunologie | |
| Schlagworte | Laboratorium • Mikrobiologie • Mikrobiologie, Handbuch/Lehrbuch • Mikrobiologie, Methoden |
| ISBN-10 | 3-8274-1072-X / 382741072X |
| ISBN-13 | 978-3-8274-1072-6 / 9783827410726 |
| Zustand | Neuware |
| Informationen gemäß Produktsicherheitsverordnung (GPSR) | |
| Haben Sie eine Frage zum Produkt? |
Mehr entdecken
aus dem Bereich
aus dem Bereich
Bestimmung und Differenzierung von Sprosspilzen, Schimmelpilzen, …
Buch | Softcover (2024)
Lehmanns Media (Verlag)
CHF 27,90
Buch | Softcover (2024)
medhochzwei Verlag
CHF 124,60
Buch | Softcover (2018)
Wiley-VCH (Verlag)
CHF 79,95


